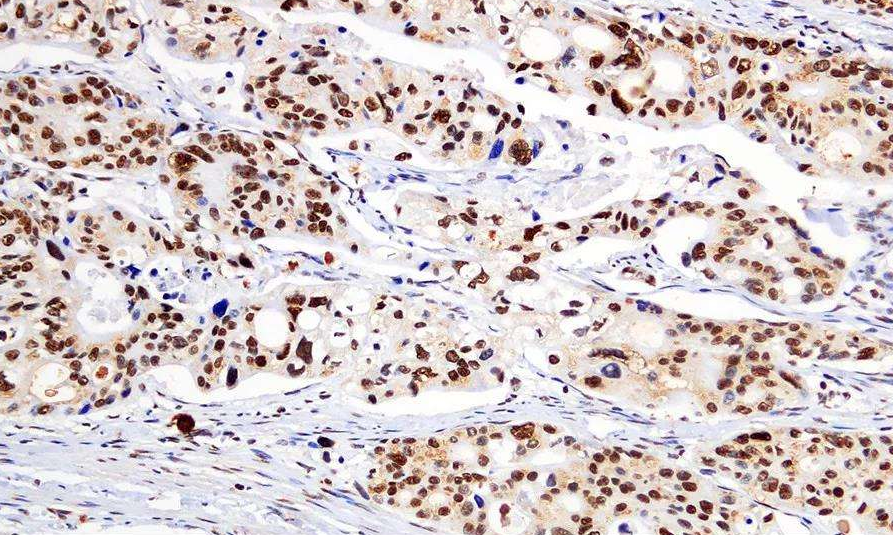

微信扫描二维码,点击右上角 ··· 按钮
转发给朋友或分享到朋友圈
明美定制灰度图像分析软件助力领域多元化发展
发布时间:2026-03-10
访问量:120
在计算机领域中,把每个像素只有一个采样颜色的图像称为灰度数字图像,换句话说,灰度图像就是没有色彩的图像。灰度图像虽然没有色彩,但并不是简单的黑白,它的设计初衷是要储存记录更丰富、更细腻、更深的层次
以一个1024像素的8bit的RGB图像来说,每个8bit颜色有2^8=256个层次,有RGB三色,总数据量是8bitx3x1024=24576bit=24byte.
256个较深的层次不能很好地还原现实,所以灰度图像牺牲颜色换图像位深到16bit,每个16bit像素有2^16=65536个层次,层次细腻度大幅提升,且同样1024像素,总数据量更小,16bitx1x1024=16byte,更便于储存阅读。
灰度的概念晦涩难懂,但是它的应用在生活中却不鲜见,在医学、图像识别领域有很广泛的用途。比如我们在医院体检时拍摄的CT(电子计算机断层扫描)、MR(磁共振检查)、B超、X光都是灰度图像,以灰阶即亮度模式的形式来诊断病症。

IHC技术现在是很成熟的方法,但是对IHC照片的分析并没有一个威势的说法,镜下观察免IHC的样品,细胞核被染上蓝色,胞浆间有(强阳性的地方会呈现棕黄色)用肉眼观察IHC切片的结果只能是定性的,不准确的,使用灰度值定量或半定量对照片测量出一个数值,在准确性和说服力上比起肉眼观察主观判断有了明显的提升。
此外,基于物体的边缘呈现灰度的不连续性的原理还可以进行图像分割,常用于生物医学图像的分析,用于测量人体器官、组织或病灶的体积,用于医学图像的3D重建,例如两个彗星细胞粘连的情况,提出一种基于区域灰度值的路径探测方法.对粘连细胞进行分割,便于可视化,可取得较理想的分割效果。另外,也可以用灰度值实现显微图像的细胞计数判读。

灰度图像拍摄与判读目前多数是用独立的两个软件进行拍摄与图像处理分析,将图像拍摄成特定的格式后通过分析软件转换深度实现灰度分析,软件来回切换给使用者带来很大的不便。广州明美可定制兼容8、12位深度拍摄和灰度识别的软件,在同一个软件上实现灰度图像拍摄及灰度识别分析,填补了市场空白,便捷性与实用性大大提升。
下图为中空毛细管在明美显微镜下的12位图①灰度分析图片,以熔融石英毛细管为Immunoassay载体材料, 通过化学发光成像和灰度分析, 建立了血清特定物质的定量Immunoassay检测方法。基于毛细管为载体的灰度分析immunodetection方法 适用化学发光Immunoassay, 具有普适性和较好的临床检验应用前景,为体外诊断的普及及准确性提供强有力的支撑。

注释:①RGB色彩模式是工业界的一种颜色标准,是通过对红(R)、绿(G)、蓝(B)三个颜色通道的变化以及它们相互之间的叠加来得到各式各样的颜色的,几乎包括了人类视力所能感知的所有颜色。例如::一个256级灰度的图象,如果RGB三个量相同时,如:RGB(100,100,100)就代表灰度为100,RGB(50,50,50)代表灰度为50。
②所谓颜色或灰度级指黑白显示器中显示像素点的亮暗差别,在彩色显示器中表现为颜色的不同,灰度级越多,图像层次越清楚逼真。灰度级取决于每个像素对应的刷新存储单元的位数和显示器本身的性能。如每个象素的颜色用16位 [2] 二进制数表示,我们就叫它16位图,它可以表达2的16次方即65536种颜色。如每一个象素采用24位二进制数表示,我们就叫它24位图,它可以表达2的24次方即16777216种颜色。
微信扫描二维码,点击右上角 ··· 按钮
转发给朋友或分享到朋友圈